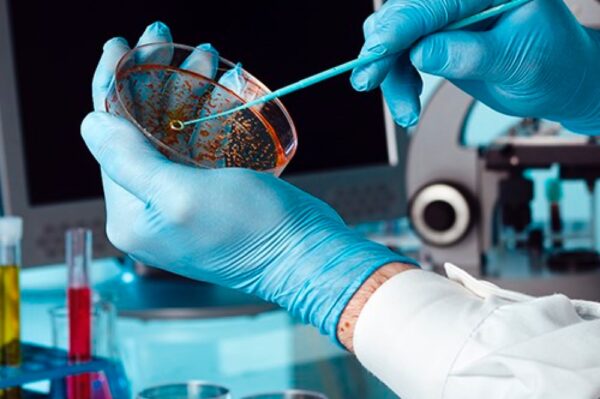
Image_TEC_INS_Biokar_Reagents_1000x665_JPG Image_TEC_INS_Biokar_Reagents_1000x665_JPG

Biokar – Microbiology – Reagents, Supplements and Additives
Biokar Diagnostics is the microbiology division of the Solabia group, dedicated to the development, production and selling of culture media, supplements and detection kits for microbiology laboratories.
Biokar Diagnostics, a division of the Solabia group, develops and produces microbiological reagents, supplements, and additives, including Coagulase Rabbit Plasma, Ringer’s Solution 1/4 strength, Synthetic Sea Salt, and Chloramphenicol Selective Supplement 50 mg, for laboratory use.
Available Models
Culture Media Production by BIOKAR Diagnostics
BIOKAR Diagnostics is an industry leader with 50 years of experience in microbiology and we got a chance to visit their factory! Follow Julien Pastor from DKSH Technology and Athanassios Giannakopoulos from BIOKAR to visit this modern factory and learn their production of culture media, from peptones to ready-to-use media.
Key Industries
- Agriculture
- Cosmetics & Personal Care
- Education & Academics
- Environmental
- Food & Beverage
- Medical
- Pharmaceutical
More Products
Biokar Diagnostics is the microbiology division of the Solabia group, dedicated to the development, production and selling of culture media,…